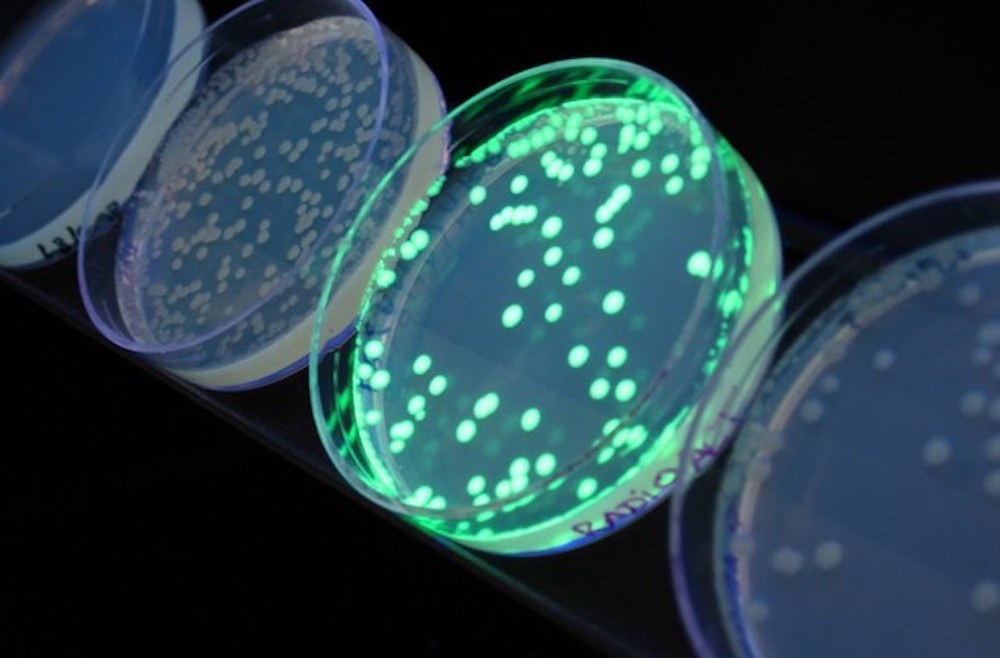
转gfp菌落

发布时间:2024-03-04 13:00:35 人气:1120 来源:析浦(上海)科学仪器
通过在琼脂平板或培养皿等凝胶生长介质上培养细菌,可以使研究人员识别菌落特征。科研人员可以通过各种染色和成像方法观察细菌或其他微生物菌落。
绿色荧光蛋白(green fluorescent protein, GFP)是维多利亚多管发光水母(也称为“水晶水母”)产生的蛋白质。GFP在可见光谱的绿色区域发出生物发光。如今,GFP 已被克隆并在分子生物学中普遍用作基因表达的荧光标记。当受到蓝光或紫外线 (UV) 激发时,GFP会发出明亮的绿光(λ max = 510 nm)。绿色荧光蛋白GFP在许多物种中表达,包括酵母、细菌、鱼类、真菌和植物。GFP表达的一个优点是高度敏感,因此可用于细胞功能的可视化分析,例如信号转导(signal transduction)、蛋白质翻译(protein translation)和DNA复制(DNA replication)。
一个快速观察转GFP的菌落的方法是使用荧光蛋白观察箱GFPfinder-2106RB
荧光蛋白观察箱GFPfinder-2106RB包含一台高强度荧光蛋白激发光源(激发光波长440-460nm,可激发GFP和EGFP发出荧光),一个便携暗箱,和一片黄色滤光片。全黑暗箱搭配滤光片,可隔绝环境光线的干扰,更清晰地观察菌落的GFP荧光。

观察转GFP的菌落,可参考以下步骤:
将细菌样品移至琼脂平板上
均匀地铺展样品
孵化:等待菌落在表面生长
将菌落放入荧光观察箱GFPfinder-2106RB
打开荧光蛋白激发光源,照射菌落
透过荧光观察箱上方的滤光片,观察菌落的GFP表达情况
透过滤光片,可拍照记录转GFP菌落的荧光表达
上海析浦专业生产荧光蛋白激发光源,可激发菌落、菌液和其他微生物中的荧光蛋白,如果您想快速检测菌落或菌液中的荧光蛋白表达,请和析浦科学仪器联系。